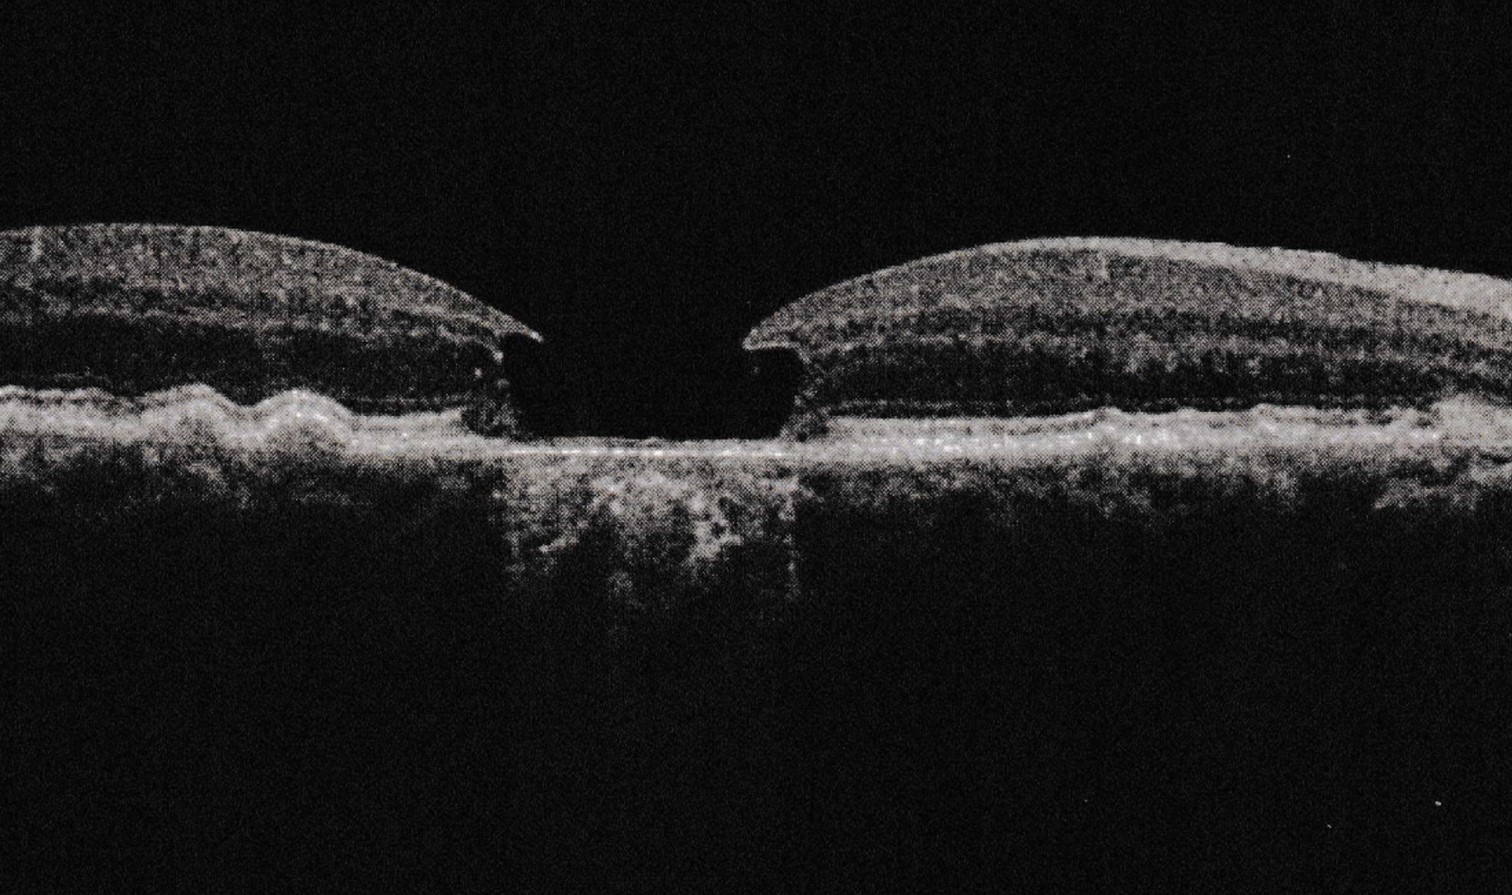

I remember the first moment when
the ophthalmologist told me my macular
degeneration in one eye had gone
from dry to wet. I probably felt momentary fear.
I had read enough to know that when one eye
goes, there is a fair likelihood the other
will eventually follow, and wet AMD
generally results in blindness.
I have lost central vision in that eye
but the fear was quickly replaced
by a desire to see everything clearly,
to enjoy the palette of colors that nature
offers up so often overlooked.
And there was the knowledge that
even if the sight in the other eye went,
the words that had gotten me through
life and career would not care about
my ability to see them, and they would
continue to demand being said, and
my fingertips would see far more
than I had ever possibly imagined.
Leave a comment